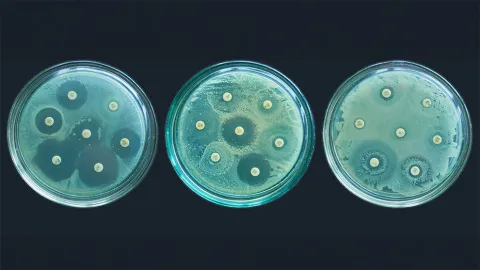
Presentan proyectos para combatir la resistencia antimicrobiana.

México.- Para combatir la resistencia antimicrobiana, esa pandemia silenciosa que avanza en el planeta sobre todo por la inadecuada prescripción médica y el abuso en el consumo de antibióticos, en el Instituto de Química (IQ) de la UNAM desarrollan vacunas, nuevas moléculas y novedosos fármacos, entre otras investigaciones que buscan enfrentar ese desafío de alcance global.
“Tenemos que seguir generando herramientas científicas para combatir bacterias, virus y hongos que han causado muchas muertes a lo largo de la historia de la humanidad”, planteó Luis Demetrio Miranda Gutiérrez, director del IQ.
Al inaugurar el “Lanzamiento de los proyectos antimicrobianos del Instituto de Química 2025”, señaló que es muy importante reconocer que la batalla que libramos contra esos microorganismos seguirá siendo muy relevante, pues son los asesinos más temidos por la población humana, y evolutivamente siempre se están defendiendo de las armas o estrategias que se desarrollan para combatirlos.
En la Biblioteca Jesús Romo Armería de esa entidad, Miranda Gutiérrez encabezó una jornada académica en la que se presentaron seis proyectos universitarios para afrontar la resistencia antimicrobiana.
Éstos son: el desarrollo integral de vacunas y estrategias antivirulencia para combatir infecciones por bacterias resistentes; una innovación terapéutica basada en aceites vegetales no comestibles para fortalecer el tratamiento del pie diabético con infecciones resistentes a los antibióticos; y la identificación computacional de compuestos con potencial actividad antibacteriana entre cepas resistentes de Pseudomonas aeruginosa, bacteria que causa una variedad de infecciones, especialmente en personas con sistemas inmunitarios debilitados, quemaduras graves, heridas quirúrgicas o enfermedades pulmonares.
Las otras investigaciones desarrolladas por especialistas del IQ se refieren al diseño, síntesis y evaluación biológica de nuevos fármacos contra patógenos bacterianos ESKAPEE (acrónimo en inglés de un grupo de seis bacterias causantes de infecciones nosocomiales o adquiridas en hospitales); el uso de minería genómica para descubrir nuevas moléculas antimicrobianas; y la vigilancia de la resistencia a los antimicrobianos basada en la secuenciación para la intervención integrada de la salud pública en la Ciudad de México.
“La resistencia antibacteriana es una crisis global que exige respuestas urgentes y sostenibles, y es lo que nosotros intentamos hacer”, comentó Corina Diana Ceapa, investigadora del IQ y líder del Laboratorio de Microbiología de esa entidad.
Se necesita trabajo conjunto para generar alianzas y construir redes que potencien los resultados de los proyectos. “Queremos que este evento sea un espacio de conexión entre nosotros, para conocer y escuchar a personas que tienen intereses comunes”, consideró también la coorganizadora del evento.
Amenaza global
“Lo que alguna vez fue una victoria médica (el desarrollo de los antibióticos), hoy se está convirtiendo en una amenaza global”, alertó Carol Siseth Martínez Caballero, investigadora del Departamento de Química de Biomacromoléculas del IQ.
Apoyándose en la imagen de un antibiograma (prueba de laboratorio que determina a qué antibióticos es sensible o resistente un microorganismo), explicó que en ese estudio se impregnan unos discos transparentes con antibióticos.
“Hay un halo transparente alrededor de esos discos, lo cual indica que las bacterias están siendo inhibidas en su crecimiento. Años después de esa prueba, esa misma bacteria fue probada y los antibióticos que antes tenían una inhibición clara en el crecimiento ahora no la tienen”, detalló.
Al ofrecer la conferencia magistral “Tendencias y desafíos en la investigación antimicrobiana”, Martínez Caballero reconoció que el impacto social de los antibióticos durante décadas ha sido muy positivo, a partir del uso de la penicilina, que se popularizó entre 1939 y 1945, en la Segunda Guerra Mundial. “Actualmente son esenciales para tratar infecciones de cualquier tipo, lograr cirugías exitosas, para cuidar a personas en terapia intensiva y en la agricultura y ganadería; también se usan en los animales y contra plagas en los cultivos”.
Según dos estudios publicados por la revista The Lancet en 2022 y 2024, dijo, en 2021 se reportaron 4.71 millones de muertes en el mundo atribuibles a la resistencia antimicrobiana.
“África subsahariana, sudeste asiático y Asia del sur, junto con Oceanía, son las regiones donde más cepas o más muertes por resistencia antimicrobiana se reportan. Llama la atención que América Latina y el Caribe registran un menor número de muertes comparadas con países de altos ingresos como Canadá, Estados Unidos, Alemania y Francia. ¿Será que en nuestra región estamos fallando en el reporte y en la vigilancia de esta resistencia?”, cuestionó.
Entre las perspectivas a futuro, propuso integrar la inteligencia artificial, la biología sintética y la nanotecnología; hacer una medicina personalizada basada en el microbioma (conjunto de microorganismos, genes y metabolitos que se producen en el cuerpo humano), y realizar una cooperación interdisciplinaria con políticas globales.
“Los microbios evolucionan constantemente, la diferencia está en qué tan rápido aprendamos a evolucionar nosotros”, finalizó la universitaria.
¿Quieres mantenerte a tanto de todas las noticias hoy en Puebla? ¡Explora más en nuestro portal ahora mismo!
Fotos Especial
mala